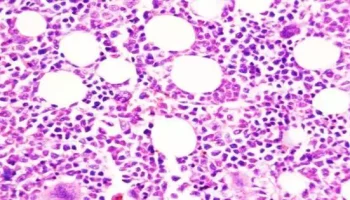

To determine the number of researchers required for a region to be a leader in a field, experts at the Intricacy Science Center tracked a
A review directed by scientists from the Gallery for Naturkunde in Berlin uncovered the development of solidification designs in the spines of four-legged vertebrates. Antoine Verrière and his partners had
A clinical examination group from the College of Hong Kong (HKUMed) has utilized amniotic liquid cells obtained during 16–24 weeks of pregnancy as an original example type for RNA-sequencing in
Intermittent fasting may aid in weight loss, lowering the risk of diabetes complications. While intermittent fasting can be done safely, people with diabetes may be at risk of hypoglycemia and
Scientists at The College of Texas MD Anderson Malignant Growth Community have found a clever immunotherapy mix, focusing on designated spots in both lymphocytes and myeloid silencer cells, that effectively